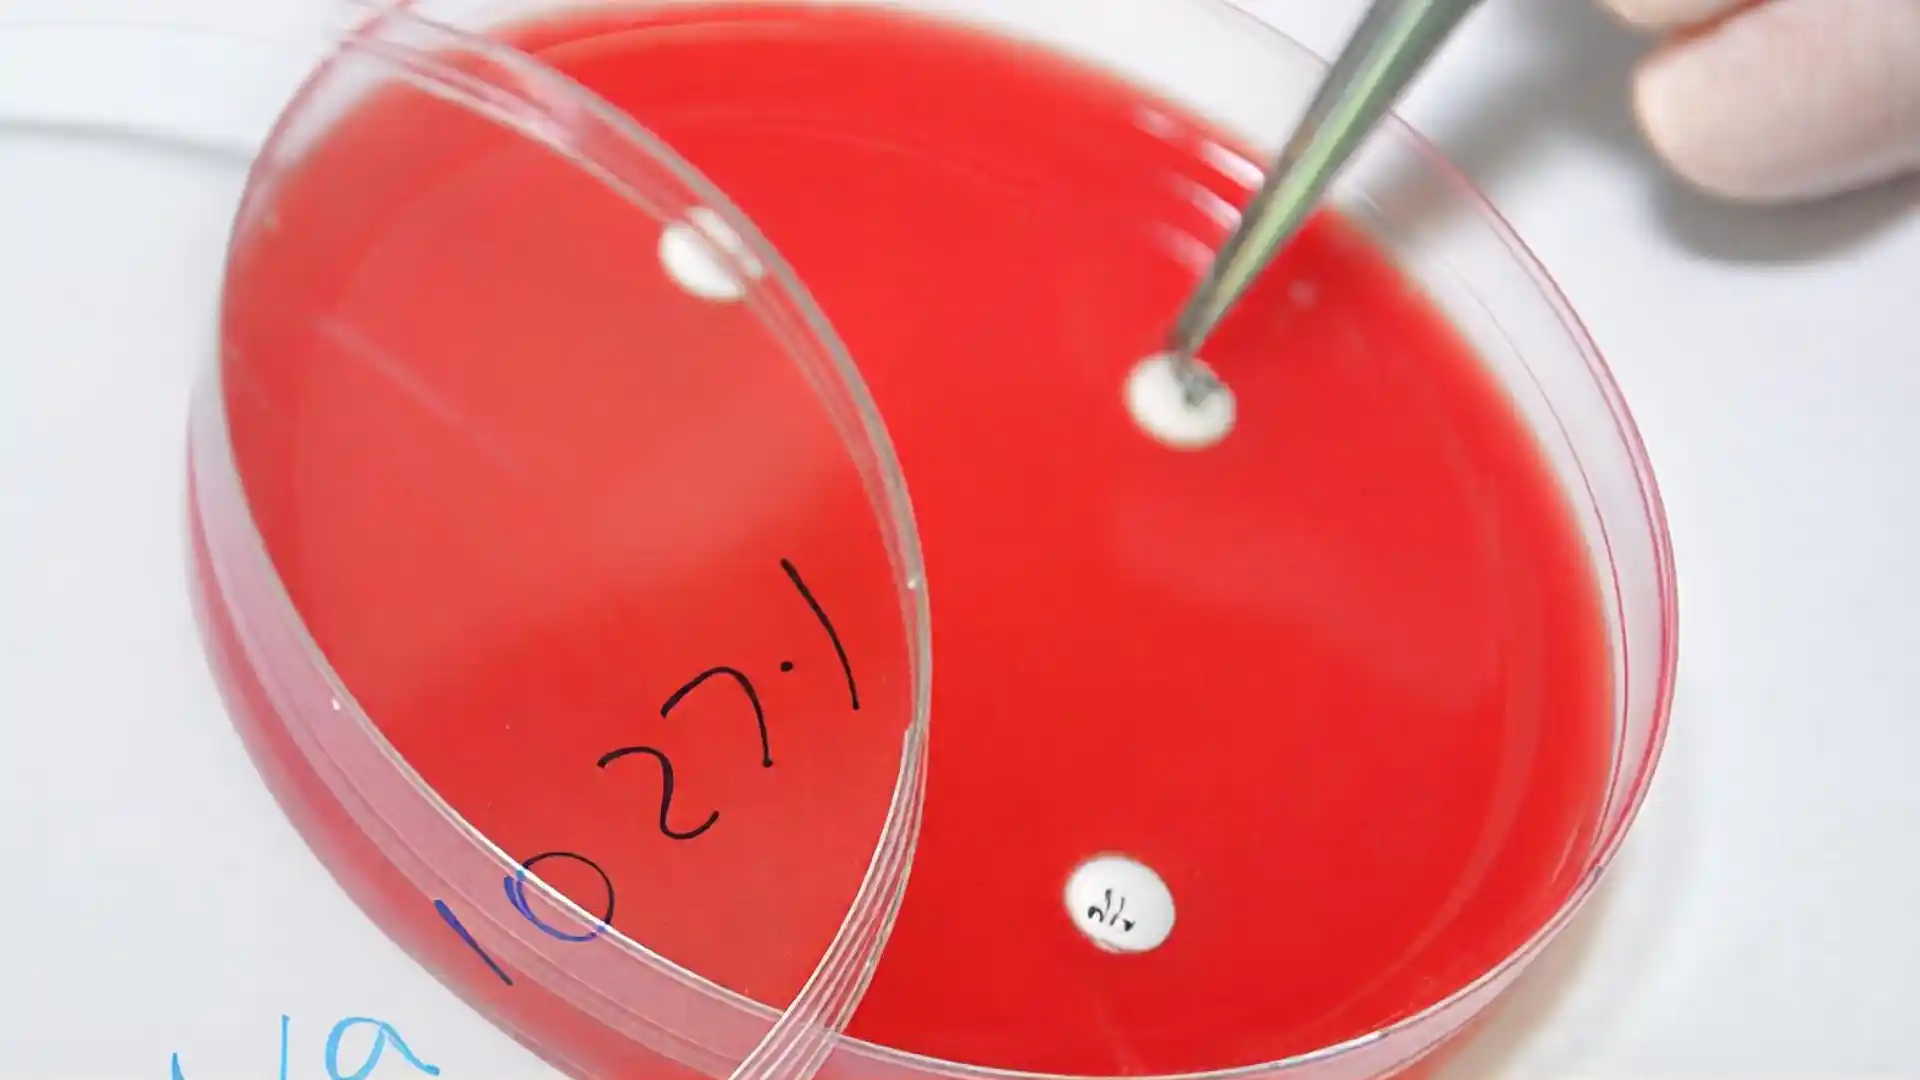

ЈАВНА УСТАНОВА ВЕТЕРИНАРСКИ ИНСТИТУТ РЕПУБЛИКЕ СРПСКЕ “ДР ВАСО БУТОЗАН”
92 годинe постојања
92 годинe искуства
92 годинe традиције
92 годинe квалитета
92 године у служби здравља људи и животиња


Контакт
Бања Лука
Aдреса: Бранка Радичевића 18
Контакт
Бијељина
Aдреса: Индустријска зона 2